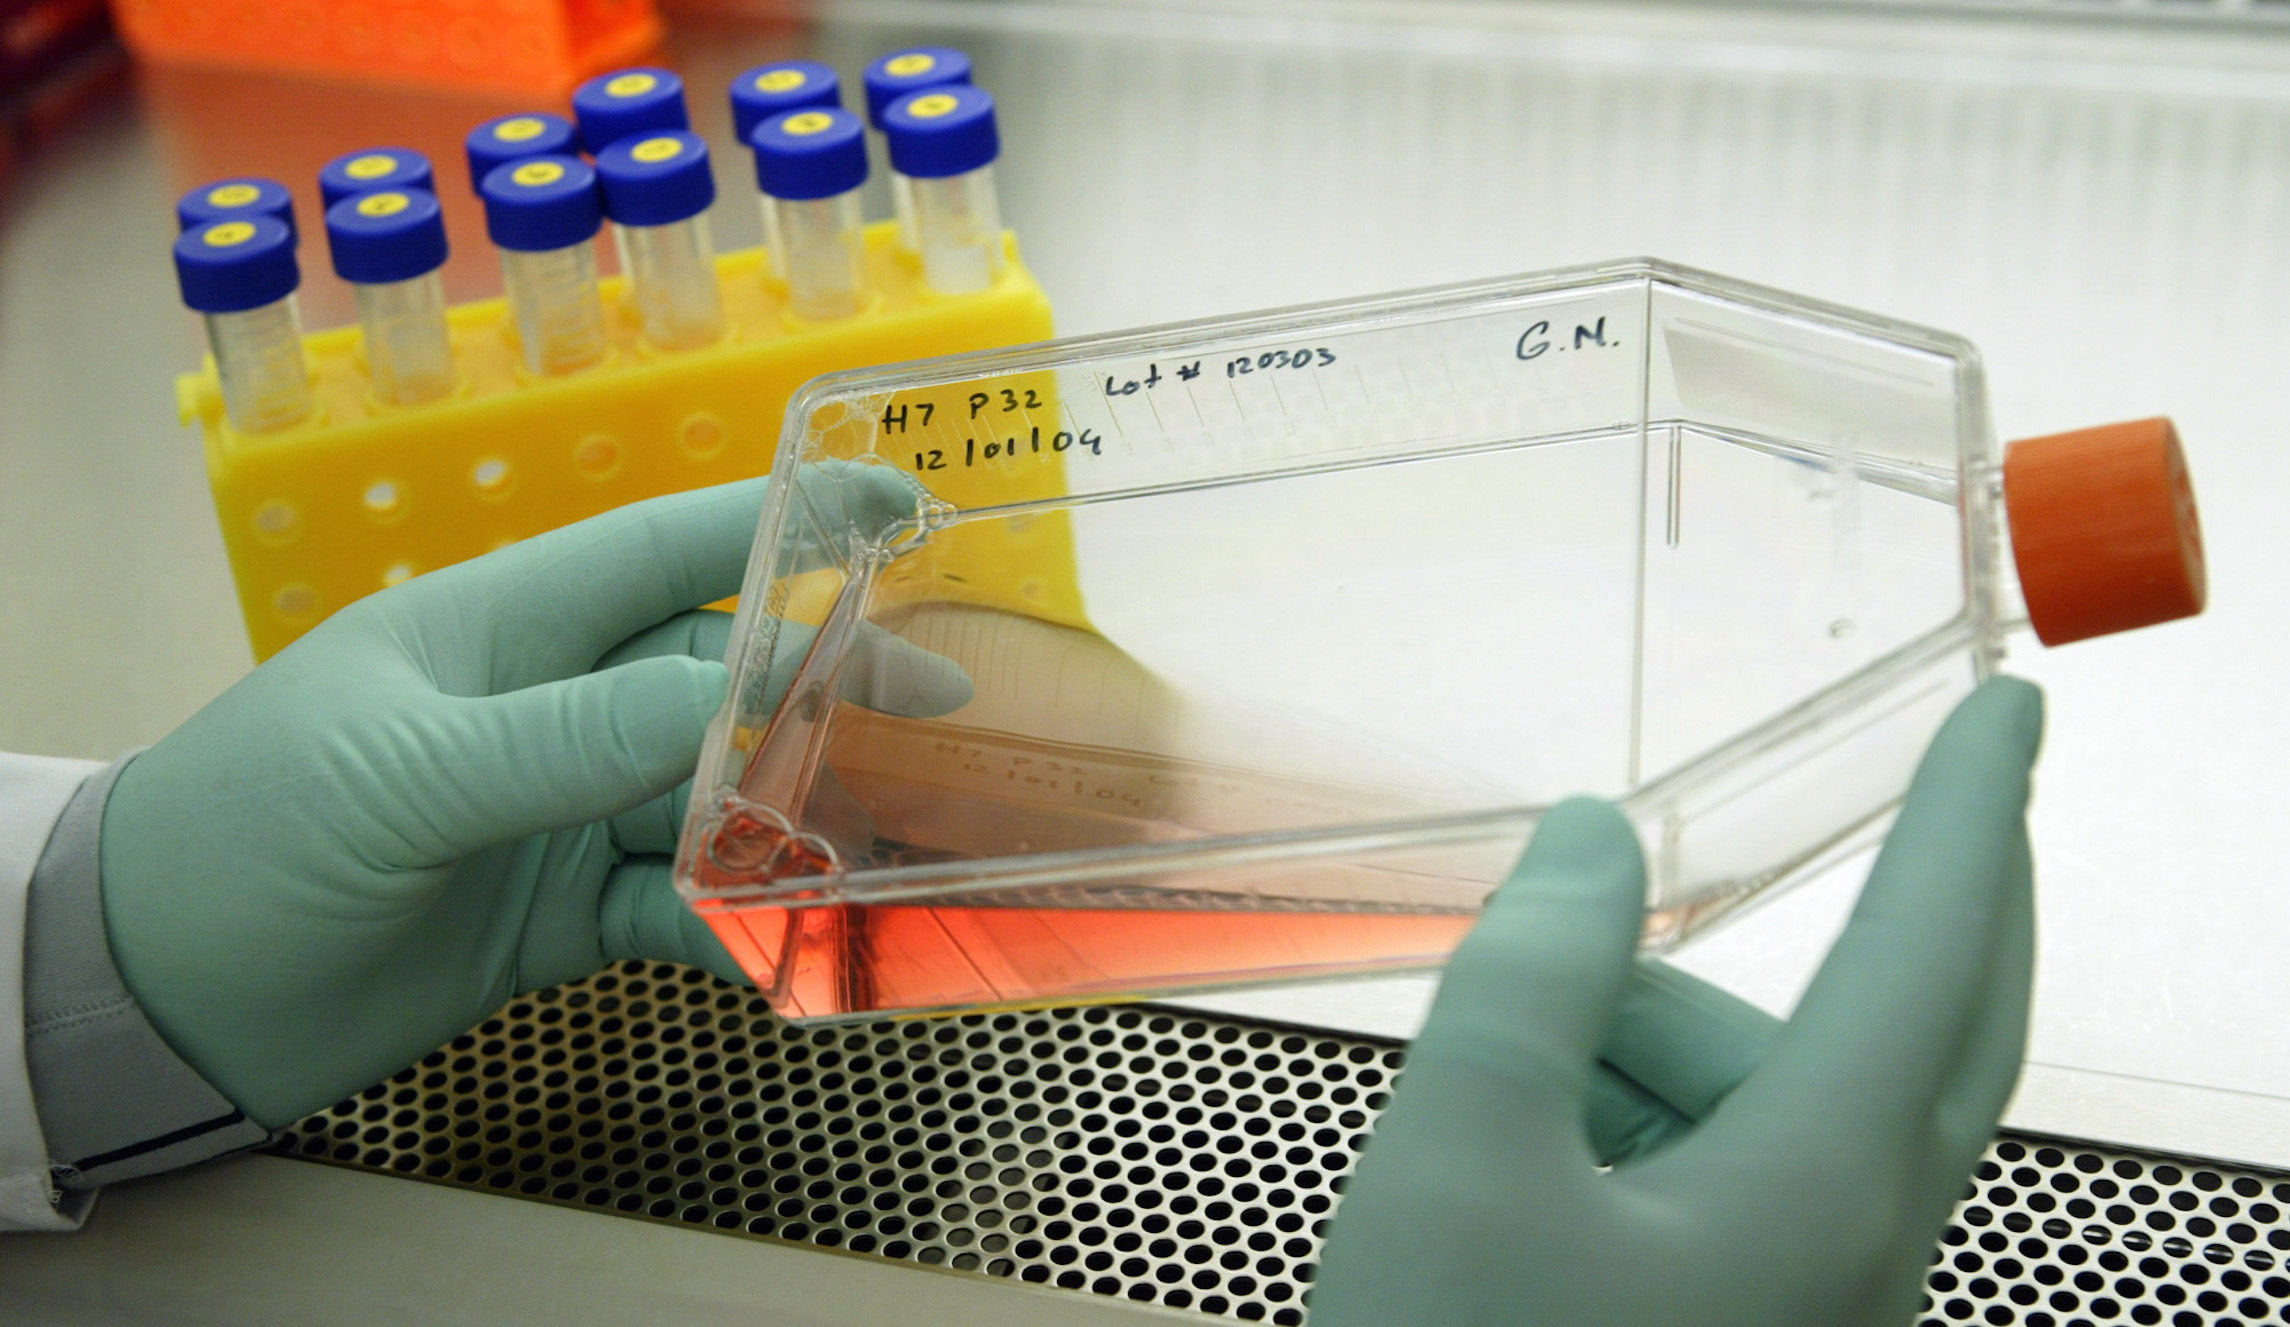
Defund grotesque taxpayer-funded human fetal tissue experiments on lab animals

This summer, the Trump Administration made the commendable decision to terminate all internal National Institutes of Health (NIH) experimentation using aborted human fetal tissue. It also canceled a controversial $2 million contract between the NIH and the University of California, San Francisco (UCSF) which required two healthy human fetuses per month from elective abortions to be used for disturbing and unnecessary taxpayer-funded medical experimentation on animals.
Jeanne Mancini, the president of March for Life, said in a statement responding to the decision, “Most Americans do not want their tax dollars creating a marketplace for aborted baby body parts, which are then implanted into mice and used for experimentation.”
Recommended Stories
She’s right. A Fox News poll found that half of Americans oppose research using human fetal tissue from aborted babies, and a Pew Research Center study shows that a majority of Americans oppose animal testing. The administration’s recent moves to curb taxpayer-funded fetal tissue research, much of which involves grotesque and wasteful animal testing, should be a cause of celebration for most people, regardless of their views on abortion or animal testing.
Our organizations — White Coat Waste Project and Pro-Life San Francisco — recently analyzed NIH spending data and related scientific publications. Unfortunately, we’ve discovered that the canceled projects are just the tip of the iceberg. While the administration’s June decision ended NIH’s internal human fetal tissue experiments and the UCSF contract it funded, it did not halt another 200 projects outside of NIH using human fetal tissue that received a combined $115 million in taxpayer funds from NIH in 2018.
Here’s how it works: First, babies are terminated at abortion clinics in university-affiliated hospitals. The remains of these unwanted children are harvested for research. College professors, eternally hungry for lucrative federal grants, solicit NIH funds earmarked for nightmarish human fetal tissue research on animals. Its big business, which is why it’s no surprise that UCSF has openly stated their hostility to any restrictions on fetal tissue research.
For instance, at UCSF, the abortion training capital of the US, experimenters recently used a $2 million government slush fund to transplant intestines removed from 18-24 week-old aborted fetuses onto the backs of 6 to 8-week-old mice. In other bizarre Frankenstein study funded by taxpayers, UCSF implanted intact reproductive tracts from 9.5 to 22-week-old human fetuses, including from a pair of aborted twins, into mice dosed with synthetic estrogen.
At the University of California-San Diego (UCSD), faculty received nearly $400,000 in taxpayer funds this year for experiments that involve implanting thymus glands from aborted human babies into mice. The mice with human fetal glands were also injected with human fetal liver cells from 17-20-week-old human fetuses. The mice were then killed and dissected. This project has received $2.7 million in taxpayer largesse since 2012 and is scheduled to run through late 2020.
Faculty from Harvard University published a taxpayer-funded experiment in which intestines harvested from 12-18-week-old human fetuses were implanted onto the intestines of live mice who were then killed and dissected after several weeks. The study was funded in part by an active NIH grant that doled out $1.5 million since 2014.
And the University of Southern California (USC) received over $2.3 million in federal grants in 2018 for experiments that have involved dissecting kidney tissue from 8 to 18-week-old human fetuses. The authors write that, “Gestational age was determined … using ultrasound, heel to toe, and crown to rump measurements.” Mice were then bred and had their fetuses cut out and the kidneys removed so that experimenters could compare them to the human fetal kidneys.
Thankfully, the Trump administration wants to further limit this outdated, wasteful, and ugly science. It has announced a common-sense plan to tighten restrictions on taxpayer-funded fetal tissue research, including on animals. It also plans to fund $20 million in research on more effective research tools, including adult stem cells, organs-on-chips and other methods using ethically-sourced human tissue.
Taxpayer-funded human fetal tissue research on animals is obviously cruel, expensive and scientifically unnecessary. As Freedom Caucus Chairman Rep. Mark Meadows, R-N.C., said last year, “What my constituents have a problem with is using their tax dollars to buy baby brains and baby eyes to do research when they find it abhorrent.”
Even in this contentious political climate, surely everyone, pro-lifers, animal lovers, Republicans and Democrats, can agree that taxpayers should not be forced to foot the bill for these disgusting human fetal tissue experiments on animals. The Trump Administration deserves everyone’s applause for its moves against this government waste and abuse.
Alyssa Canobbio Hackbarth serves on the board of directors at D.C.-based taxpayer watchdog group White Coat Waste Project. Terrisa Bukovinac is the Founder and executive director of Pro-Life San Francisco.